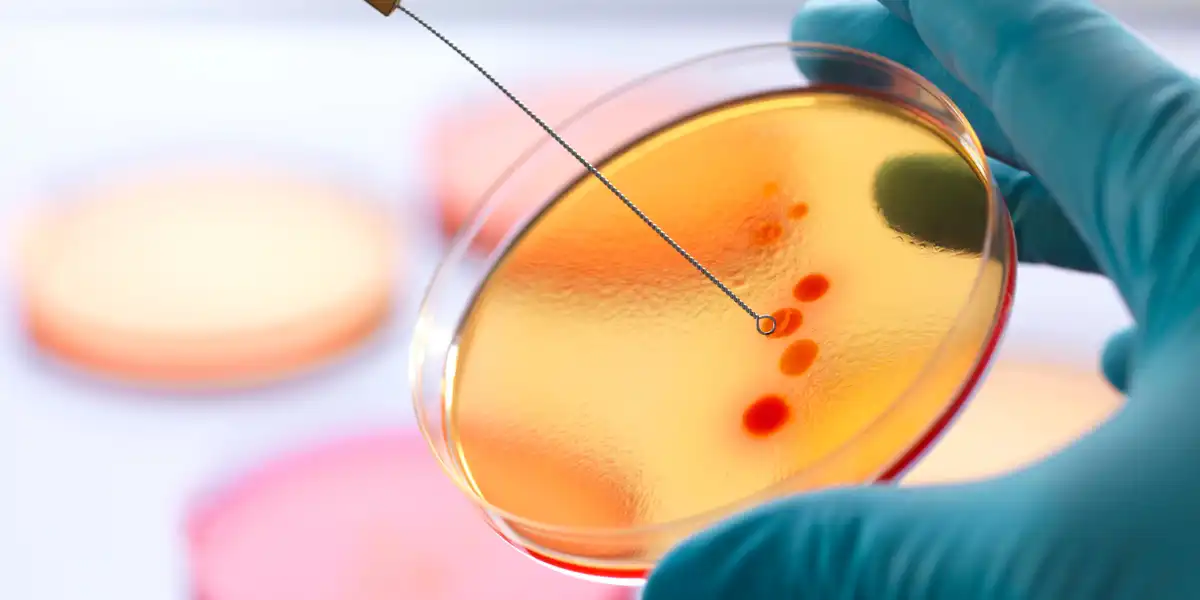

Welcome to Unichem
Chemicals and Labware Supplier
Unichem adalah perusahaan yang bergerak dalam bidang perdagangan bahan kimia dan perlengkapan laboratorium terutama yang digunakan untuk kegiatan analisa di laboratorium. Produk yang kami sediakan yaitu analytical reagent atau bahan kimia dengan grade analisa atau reagen pro-analisa (reagen PA) termasuk Certified Reference Material (CRM) yang digunakan sebagai control dalam kegiatan analisa dan bahan kimia untuk Proficiency Test (PT) atau uji profisiensi. Selain bahan kimia, kami juga menyediakan produk-produk untuk pengujian di laboratorium mikrobiologi serta produk-produk bioscience yang banyak digunakan di laboratorium biomolekuler dan bioteknologi.
Alasan Menggunakan Produk kami
Kami Memberikan Produk Dengan Kualitas Pilihan
Varian Produk Dapat Disesuaikan Dengan Alokasi Budget
Memberikan Konsultasi Produk Sesuai Kebutuhan Analisa
Term of Payment Fleksibel
Dapatkan Harga Terbaik Dari kami
Alamat
Jl. Yasin Salmah No. 1756 Palembang
Telepon
+6281367670004
unichem.arka@gmail.com
info@unichem.id













